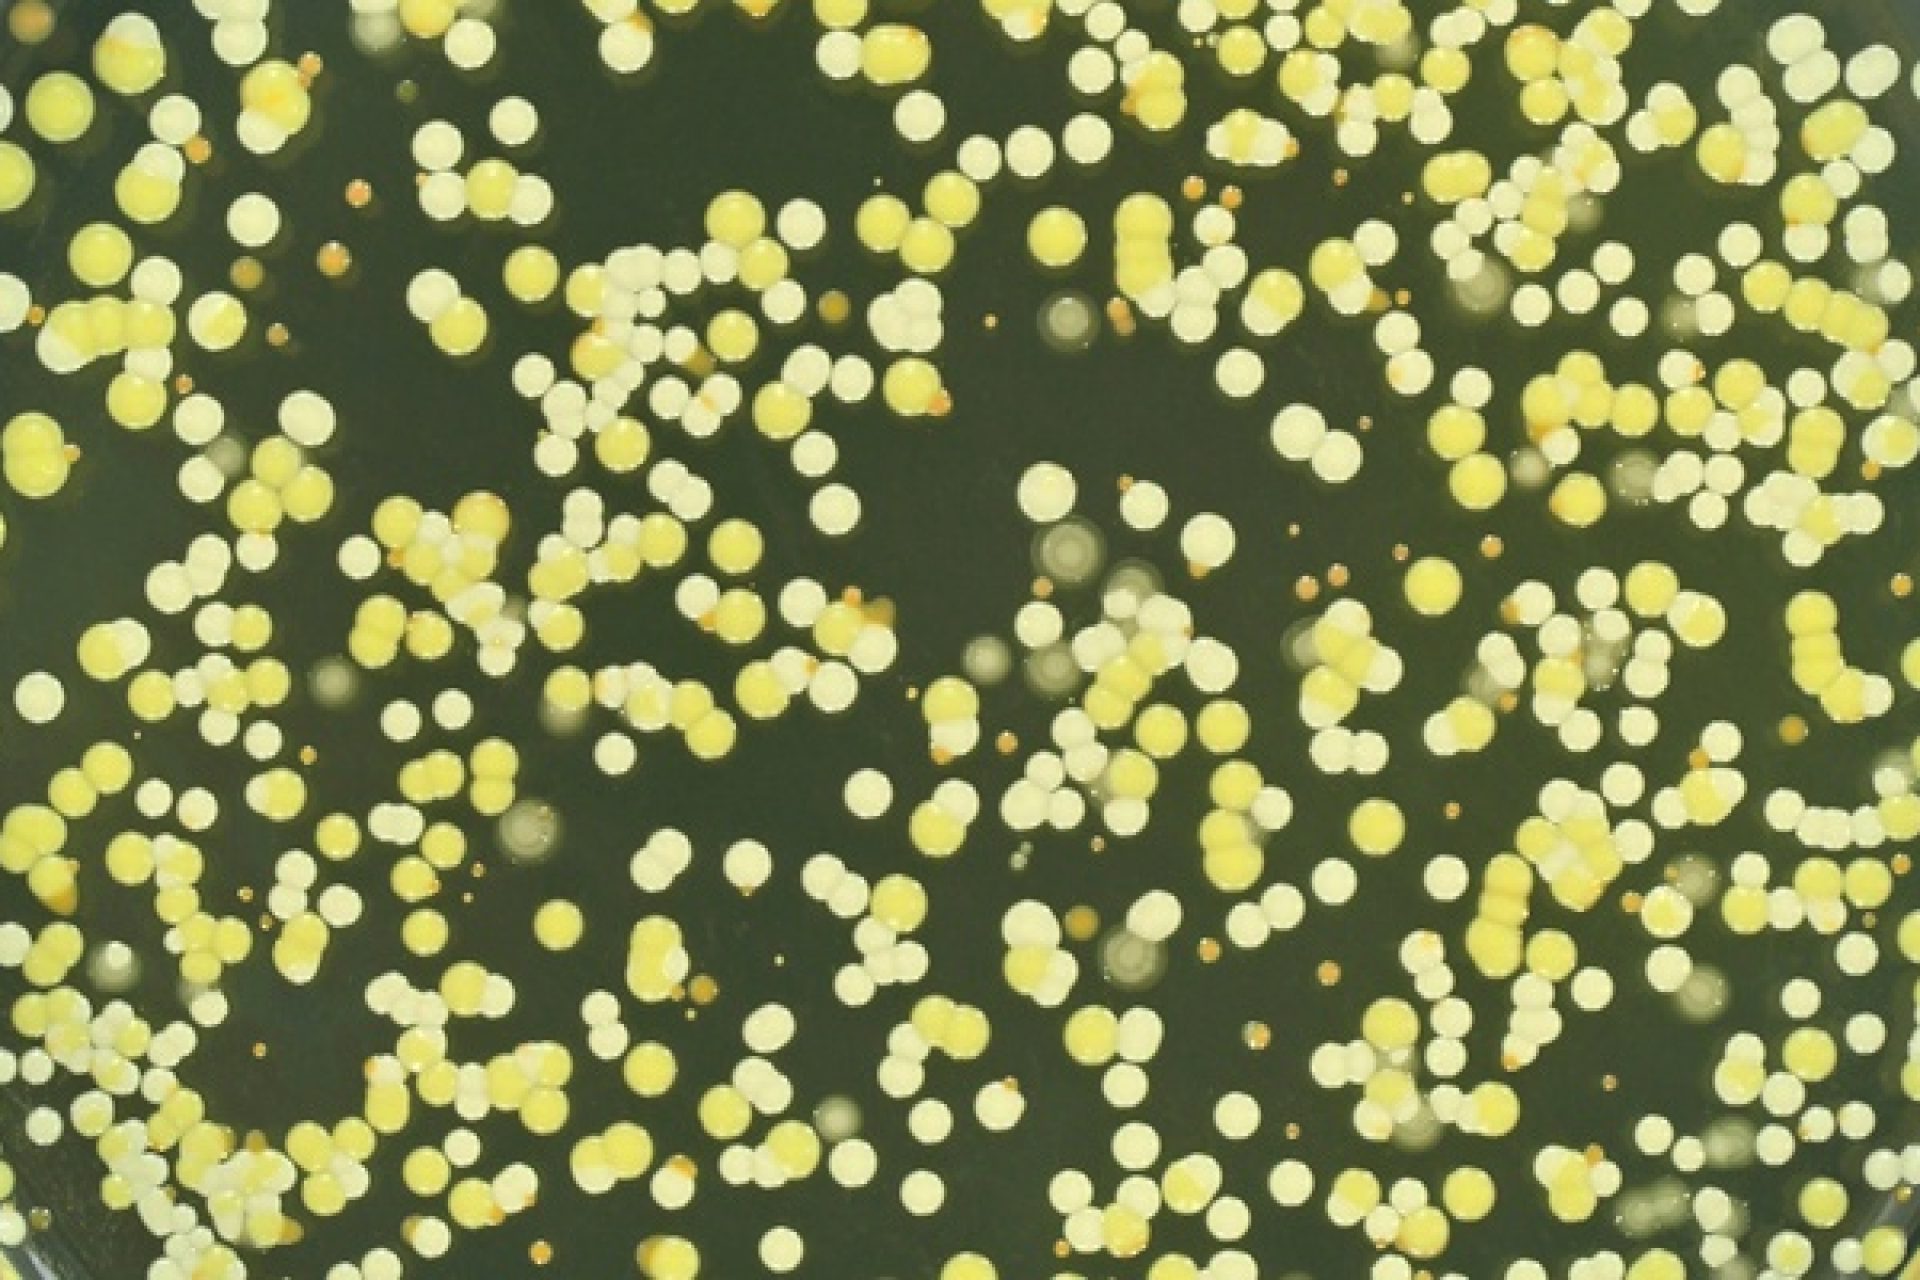
image___bacteriaweb

Scientists from the University of Leeds have solved a 25-year-old question about how a family of proteins allow bacteria to resist the effects of certain antibiotics.
Proteins of the ABC-F protein family are a major source of antibiotic resistance in ‘superbugs’ such as Staphylococcus aureus, a group of bacteria that includes MRSA.
The findings, published in the American Society for Microbiology journal mBio, provide the first direct evidence of how this family of proteins ‘protect’ the bacterial ribosome, the protein makers in cells, from being blocked by antibiotics.
Ordinarily, the ribosome is an ideal target for antibiotics because living bacteria cannot grow without it, but when bacteria produce ABC-F proteins many antibiotics no longer work.
Until now, there has been a longstanding debate as to exactly how these proteins work.
Scientists have been divided in their support for two separate ideas; that the proteins are pumps that remove antibiotics from bacterial cells, or that they interact with the bacteria’s ribosomes to stop antibiotics from blocking them.
Fundamental research of this type provides a better picture of the molecular basis for antibiotic resistance. It can offer valuable information that might be used in the future to design antibiotics to bypass antibiotic resistance, when scientists are able to understand more about the properties that allow drugs to enter bacterial cells.
Dr Liam Sharkey, a Fellow in the School of Molecular and Cellular Biology, who carried out the research, said: “These findings provide the first direct evidence that these proteins directly protect the ribosome. As a result the goal-posts of our research have changed, we can now zoom-in and try to work out the exact details of how this protection is happening.
“Our results suggest that the proteins work by removing antibiotics when they bind their targeted ribosome. It’s a bit like the proteins are bouncers at a ribosome nightclub, the bouncer’s job is to keep kicking out antibiotics that are trying to get in and cause trouble.”
This debate has been not settled until now because of the technical challenges associated with the research and much of the attention of academics in the field has been focused on the idea that these proteins are working as pumps.
The research, which was funded by the Biotechnology and Biological Sciences Research Council (BBSRC), and understanding the molecular basis for antibiotic resistance is a key focus of the Astbury Centre for Structural Molecular Biology at the University of Leeds. Further progress in this area will be boosted by new state-of-the-art facilities, enabling researchers to better understand life in molecular detail.
A pioneering tradition in structural biology
A recent £17 million investment in some of the best nuclear magnetic resonance and electron microscopy facilities in the world is now enabling scientists to remain at the forefront of research into complex proteins.
The University of Leeds has played a key role in the birth of structural biology as a scientific discipline, with the development of X-ray crystallography by Nobel Laureates William and Lawrence Bragg in Leeds in 1912-13.
A new academic symposium, the Astbury Conversation, is being hosted at the University of Leeds from 11 – 12 April 2016, to bring together leading researchers from across the globe to discuss the most recent innovations, new techniques and technologies in the field of structural molecular biology.
For more information, visit http://www.astburyconversation.leeds.ac.uk/
A public exhibition and lecture on Tuesday 12 April follows the symposium, aimed at helping people understand the secret life of molecules.
Professor Michael Levitt, who was awarded the 2013 Nobel Prize in Chemistry for developing computer-based tools to better understand and predict chemical reactions, will be delivering the talk, “How modelling molecules builds our understanding of life.”
Further information
Dr Liam Sharkey is available for interview. Contact the University of Leeds press office on pressoffice@leeds.ac.uk or call 0113 343 4031.
A copy of the paper is available on request.
Read more about the University’s investment in this area here